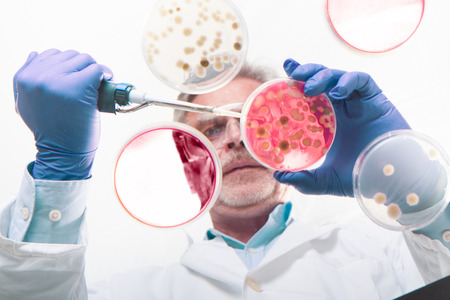
Focused senior life science professional grafting bacteria in the pettri dishes. Lens focus on the pipette. Through the glass view.の写真素材

写真素材 - Focused senior life science professional grafting bacteria in the pettri dishes. Lens focus on the pipette. Through the glass view.
作品情報
Focused senior life science professional grafting bacteria in the pettri dishes. Lens focus on the pipette. Through the glass view.
- ID:84548334
- 作品種別:写真
- 作者名:Matej Kastelic
キーワード
- analyze
- bacteria
- bio
- biological
- biology
- blue
- cell
- clinical
- close-up
- colony
- culture
- detail
- dish
- drop
- experiment
- fluid
- fungi
- gene
- genetics
- glass
- glove
- goggles
- graft
- grow
- healthcare
- laboratory
- life
- liquid
- macro
- man
- medical
- medicine
- micro
- organism
- person
- petri
- pharmacy
- pipette
- plate
- research
- researcher
- sample
- science
- scientific
- scientist
- senior
- serum
- technology
- test
- virus
類似作品
Abstract Motion...
The elderly wom...
Portrait of a s...
Close up of sen...
fascinating bio...
Senior man carr...
Elderly profess...
Covid-19 (coron...
Advanced user. ...
Doctoral work a...
A distinguished...
Hes just made a...
close up face o...
Master professi...
Professor and h...
Glass wall, sci...
Close-up Portra...
Senior observes...
Chemical indust...
Minimal portrai...
Man with 3D pri...
Senior male res...
Scientist at wo...
Old researcher ...
Microbiology sc...
Senior professo...
Professor works...
Close-up portra...
Professor and h...
Professional do...
Professor and h...
Laboratory Rese...
Artisan in his ...
Science, medica...
Science, medica...
American elder ...
Mature scientis...
Senior chemist ...
Young woman sci...
Laboratory Rese...
Portrait of eld...
Science man, pl...
Old male teache...
Young woman sci...
Portrait of sen...
Mature man, sci...
Side portrait o...
Analyzing sampl...
Smiling senior ...